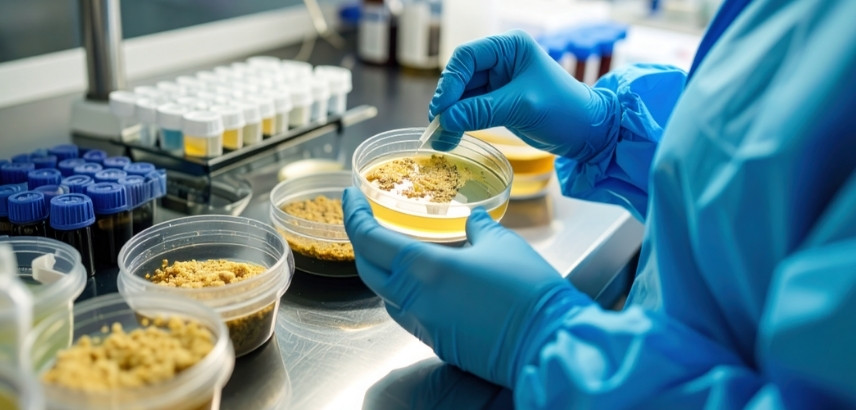

Transplante de microbiota fecal: esperança para doenças gastrointestinais
18/06/2025 17h43 – Atualizado há 4 meses
Avanços na gastroenterologia trazem novas perspectivas para o tratamento de doenças do trato digestivo. Uma técnica inovadora, conhecida como transplante de microbiota fecal (TMF), tem ganhado destaque na comunidade médica por seus resultados promissores.
O que é o transplante de microbiota fecal?
O TMF consiste na transferência de fezes de um doador saudável para o intestino de um paciente com desequilíbrio na microbiota intestinal. Essa técnica visa restaurar a diversidade e o equilíbrio das bactérias benéficas no intestino do receptor.
Aplicações do TMF
Pesquisas recentes apontam que o TMF pode ser eficaz no tratamento de diversas condições, incluindo:
- Infecção recorrente por Clostridioides difficile
- Síndrome do intestino irritável
- Doença inflamatória intestinal
- Obesidade
- Doenças metabólicas
Benefícios e riscos
O TMF tem se mostrado uma alternativa promissora para pacientes que não respondem bem aos tratamentos convencionais. No entanto, como qualquer procedimento médico, existem riscos associados que devem ser considerados:
Benefícios:
- Alta taxa de sucesso no tratamento de infecções por C. difficile
- Potencial para melhorar sintomas de outras doenças gastrointestinais
- Procedimento minimamente invasivo
Riscos:
- Possibilidade de transmissão de patógenos desconhecidos
- Reações adversas temporárias, como diarreia ou constipação
- Necessidade de mais estudos para comprovar eficácia em outras condições
O processo de seleção de doadores
A seleção criteriosa de doadores é fundamental para o sucesso e segurança do TMF. Os candidatos passam por uma série de exames e avaliações, incluindo:
- Triagem de doenças infecciosas
- Avaliação do histórico médico
- Análise da composição da microbiota intestinal
Perspectivas futuras
O campo da gastroenterologia está em constante evolução, e o TMF representa apenas uma das muitas inovações em desenvolvimento. Pesquisadores continuam investigando outras aplicações potenciais do procedimento, bem como aprimorando as técnicas de transplante.
Considerações éticas e regulatórias
À medida que o TMF ganha popularidade, surgem questões éticas e regulatórias que precisam ser abordadas. Autoridades de saúde em diversos países estão trabalhando para estabelecer diretrizes claras para a realização do procedimento, garantindo a segurança dos pacientes e a padronização das práticas.
Impacto na prática clínica
Para os profissionais de saúde, o TMF representa uma nova ferramenta no arsenal terapêutico. Médicos e pesquisadores estão se atualizando sobre as melhores práticas e indicações do procedimento, buscando oferecer aos pacientes opções de tratamento mais eficazes e personalizadas.
Conclusão
O transplante de microbiota fecal emerge como uma técnica promissora no campo da gastroenterologia, oferecendo novas possibilidades de tratamento para diversas condições. Enquanto mais pesquisas são necessárias para compreender plenamente seu potencial e limitações, o TMF já se mostra uma opção valiosa para muitos pacientes que enfrentam desafios gastrointestinais complexos.